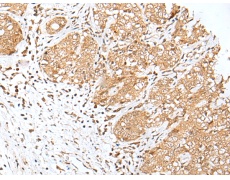
一抗

|
Background: |
This gene encodes a member of a family of transcription factors which regulate the expression of genes required for progression through the cell cycle. The encoded protein regulates progression from G1 to S phase by ensuring the nucleus divides at the proper time. Multiple alternatively spliced variants, encoding the same protein, have been identified. |
|
Applications: |
ELISA, IHC |
|
Name of antibody: |
E2F8 |
|
Immunogen: |
Synthetic peptide of human E2F8 |
|
Full name: |
E2F transcription factor 8 |
|
Synonyms: |
E2F-8 |
|
SwissProt: |
A0AVK6 |
|
ELISA Recommended dilution: |
5000-10000 |
|
IHC positive control: |
Human gastric cancer and human esophagus cancer |
|
IHC Recommend dilution: |
25-100 |


 購物車
購物車 幫助
幫助
 021-54845833/15800441009
021-54845833/15800441009